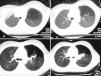
fig2

Sr. Editor:
La atresia bronquial congénita es una anomalía pulmonar poco frecuente1,2. Se debe a la falta de formación parcial de un bronquio lobular, segmentario o subsegmentario, con desarrollo normal de la vía aérea distal al defecto. Como resultado de esta estenosis, en el bronquio distal se acumulaban secreciones, formando un quiste más o menos redondeado denominado broncocele. Los alvéolos ventilados por el bronquio afectado son aireados por vías colaterales como los poros de Kohn y los canales de Lambert, mostrando un atrapamiento aéreo e hiperinsuflación alrededor del bronquio distal.
Varón de 10 años, sin antecedentes personales ni familiares de interés, que acudió a urgencias por dolor costal izquierdo de pocas horas de evolución, relacionado con un traumatismo costal leve. A la exploración física no se encontraron hallazgos patológicos salvo hipoventilación en el vértice pulmonar izquierdo. En la radiografía de tórax (fig. 1) se observó una imagen cavitada en la región parahiliar izquierda, sin visualización de atrapamiento aéreo. La tomografía computarizada (TC) torácica mostró una hiperclaridad pulmonar con disminución de la vascularización en el lóbulo superior izquierdo (fig. 2). A nivel hiliar izquierdo y justo encima de la salida del bronquio del lóbulo superior izquierdo se apreciaba una imagen seudonodular de 2 cm de diámetro. Mediante contraste se observó una doble luz de contenido líquido de + 5 u/H en los dos tercios inferiores. La fibrobroncoscopia practicada fue normal. En la gammagrafía pulmonar de ventilación-perfusión se observaron defectos concordantes en la perfusión y ventilación de tipo subsegmentario en porciones anteriores del segmento apical y en segmento anterior del lóbulo superior izquierdo. El estudio de la función pulmonar tuvo un resultado normal, con volumen espiratorio máximo en el primer segundo (FEV1) del 85,1 %, capacidad vital máxima (FVC) de 79,9 % y FEV1/FVC de 105,1 %.
Figura 1. Radiografía de tórax en la que se aprecia una imagen cavitada en la región parahiliar izquierda. No se visualiza atrapamiento aéreo.
Figura 2.TC pulmonar en la cual se evidencia en los cortes pulmonares altos la hiperclaridad pulmonar con disminución de la vascularización, que afecta al lóbulo superior izquierdo. A nivel hiliar izquierdo y, justo encima de la salida del bronquio del lóbulo superior izquierdo, se aprecia una imagen seudonodular de 2 cm de diámetro. Mediante contraste se evidencia la doble luz de contenido de + 5 u/H en los dos tercios inferiores.
La atresia bronquial congénita fue descrita por primera vez por Ramsey en 19533. El bronquio afectado con mayor frecuencia es el apical posterior del lóbulo superior izquierdo en el 64 % de los casos, seguido del lóbulo inferior izquierdo en el 14 % y el lóbulo inferior y medio derecho sólo en el 8 %. La predilección por el lóbulo superior izquierdo es compartida con otras alteraciones congénitas como la agenesia, la hipoplasia o el secuestro, lo cual puede ser atribuido a su inestabilidad embrionaria4.
Los pacientes generalmente están asintomáticos en el momento del diagnóstico, siendo un hallazgo radiológico aislado y casual, aunque puede cursar con infecciones respiratorias recurrentes, tos, disnea e incluso hemoptisis4-7. La mayoría de los casos se han descrito en adultos jóvenes con un predominio en el varón en una proporción 2:1. Aunque la atresia bronquial congénita es un hallazgo aislado, se ha descrito asociada a diversas malformaciones pulmonares, defectos pericárdicos, retorno venoso pulmonar anómalo y, recientemente, con arteria pulmonar derecha epibronquial y arteria pulmonar media derecha aberrante, etc.8.
Los hallazgos radiológicos pueden mostrar una masa hiliar en el 89 % de los casos (6), un área de hiperlucidez pulmonar en el 67 %6 o una asociación de ambos en el 67 %6. La hiperlucidez es el resultado de la asociación de la oligohemia y un incremento del volumen de aire en el parénquima afectado. La acumulación de secreciones y su enclavamiento en el extremo distal de la atresia determina la aparición de opacidades ovaladas, redondas o ramificadas cerca del hilio, constituyendo el mucocele. Es posible diagnosticar la atresia bronquial congénita con sólo una radiografía de tórax (6). En el caso que se presenta, en la radiografía (fig. 1) sólo se percibe una imagen cavitada parahiliar sugerente de broncocele, sin área de hiperlucidez asociada.
La TC torácica permite la visualización del broncocele, de la hiperinsuflación segmentaria y de la hipovascularización. La combinación de todos ellos puede considerarse diagnóstica de atresia bronquial congénita. La TC es hoy día el procedimiento diagnóstico de elección5,9, puede demostrar la ausencia de comunicación entre el broncocele y el hilio y es más sensible que la radiografía simple en la demostración de la hiperinsuflación pulmonar4. La TC con contraste permite excluir anomalías vasculares sin la necesidad de realizar una angiografía pulmonar. La TC en espiración puede demostrar el atrapamiento aéreo10.
Otros métodos diagnósticos como la resonancia magnética quedan reservados como segunda modalidad en el diagnóstico por imagen tras la TC, cuando ésta no es concluyente6. Aunque en la atresia bronquial congénita la fibrobroncoscopia suele ser normal5 deberá ser realizada para descartar otras lesiones responsables de una obstrucción bronquial que pueda reproducir la misma imagen radiográfica. La gammagrafía de perfusión demuestra una hipovascularización en la zona del parénquima pulmonar afectado y la de ventilación pone en evidencia el retraso en la aireación de dicha zona.
El broncocele se puede considerar uno de los hallazgos más importantes en el diagnóstico de esta entidad, pero puede aparecer también en casos de obstrucción adquirida (cuerpos extraños, granulomas por tuberculosis, neoplasias, etc.) y en la aspergilosis broncopulmonar alérgica5,7. A su vez, hay que plantear un diagnóstico diferencial de la atresia bronquial congénita con anormalidades vasculares, secuestro intralobular, quistes pulmonares, etc.
La ecografía fetal permite el diagnóstico de atresia bronquial congénita intraútero11,12.
El tratamiento tradicional, la resección quirúrgica del área afectada, se reserva actualmente para aquellos casos que se acompañen de complicaciones como una infección respiratoria.